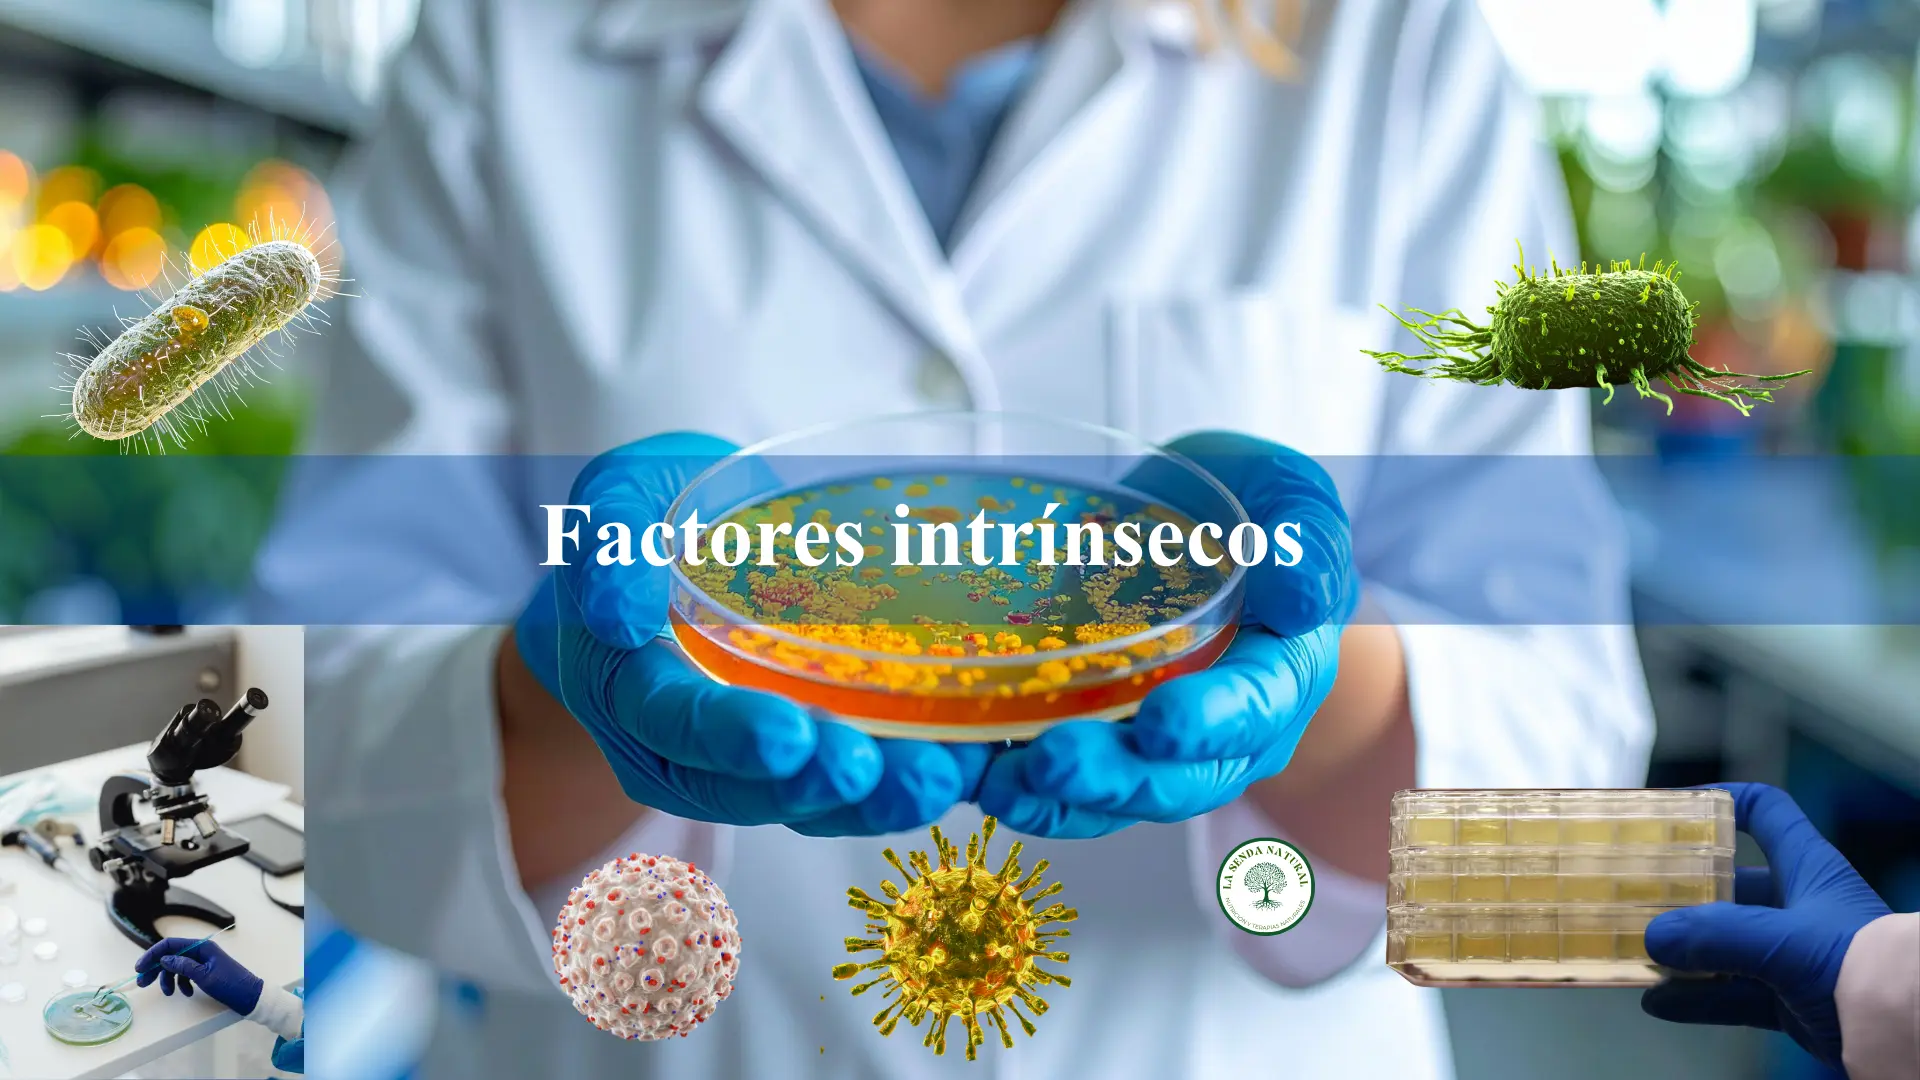
Factores intrínsecos

MICROBIOLOGÍA DE LOS ALIMENTOS
Resumen:
La microbiología de los alimentos estudia los microorganismos presentes en los alimentos, su papel en la alteración, fermentación y los riesgos para la salud humana. El crecimiento microbiano depende de factores intrínsecos, extrínsecos, implícitos y de elaboración, que permiten diseñar estrategias de control y prevención.
Introducción
La microbiología de los alimentos es la disciplina que analiza la presencia, crecimiento e impacto de los microorganismos en los alimentos. Estos microorganismos pueden ser beneficiosos (fermentaciones), alterantes (deterioro del alimento) o patógenos (riesgo para la salud humana). La comprensión de los factores que modulan su crecimiento permite aplicar medidas eficaces de control higiénico-sanitario y prevención de toxiinfecciones alimentarias.
¿Qué son los microorganismos en los alimentos?
Los principales grupos de interés son:
-
Bacterias: pueden ser beneficiosas (probióticas), alterantes o patógenas.
-
Hongos y levaduras: responsables de fermentaciones y alteraciones.
-
Virus y parásitos: asociados a contaminación fecal-oral y alimentos mal procesados.
Definición clave:
Los microorganismos alimentarios pueden clasificarse como saprofíticos, beneficiosos o patógenos, y esta clasificación determina las estrategias de control.
Factores que influyen en el crecimiento microbiano
Factores intrínsecos (limitaciones del sustrato)
-
Disponibilidad de nutrientes: cantidad y tipo de nutrientes accesibles.
-
pH: la acidez o alcalinidad condiciona la supervivencia microbiana.
-
Actividad del agua (aw): agua disponible para el metabolismo.
-
Componentes antimicrobianos: sustancias naturales o añadidas con efecto inhibidor.
-
Potencial redox (Eh): capacidad oxidante/reductora del medio.
Factores extrínsecos (limitaciones ambientales)
-
Humedad ambiental
-
Temperatura de conservación
-
Atmósfera gaseosa (O₂, CO₂, atmósferas modificadas)
-
Velocidad de crecimiento específico del microorganismo
Microorganismos y alimentos
Los microorganismos están presentes en el medio ambiente natural del ser humano: el aire, el agua o el suelo; en el propio ser humano y en todos los seres vivos, tanto los animales como las plantas de los que se alimenta. En realidad, los alimentos que consumimos rara vez son estériles; contienen asociaciones microbianas cuya composición depende de los gérmenes que son capaces de llegar hasta ellos, sobrevivir, proliferar e interaccionar con sus componentes.
Según el tipo de microorganismos implicados, la contaminación tendrá consecuencias más o menos importantes, que pueden ir desde la simple alteración del producto, con modificación de sus características organolépticas, comerciales o nutricionales, hasta la aparición de intoxicaciones y toxiinfecciones graves en el consumidor.
No hemos de olvidar el efecto positivo o buscado en algunos casos, como el acabado de aroma y sabor o fermentación de algunos productos.
Orígenes de la contaminación de los alimentos
Es posible encontrar microorganismos vivos en una diversidad de hábitat con características muy extremas.
Por ejemplo, existen bacterias en fumarolas volcánicas submarinas a temperaturas superiores a 104°, en aguas residuales ácidas de industrias o minerías, en raíces de plantas, en el intestino de animales, etc. Así pues, la ubicuidad de los microorganismos es muy alta lo que significa que las fuentes de contaminación de los alimentos serán variadísimas, desde las materias que los van a constituir y su medio ambiente natural hasta los microorganismos introducidos durante los procesados y manipulaciones tecnológicas, el transporte y el almacenamiento.
Factores que influyen en la multiplicación de los microorganismos en los alimentos.
- Factores intrínsecos.
- Factores extrínsecos.
- Factores implícitos.
Contaminación de microorganismos a partir del aire
En líneas generales, se puede afirmar que uno medios más hostiles para la supervivencia de los organismos es el medio atmosférico, ya que en él los gérmenes están expuestos a la actividad del oxígeno gaseoso, a la radiación solar, a variaciones en la humedad relativa del aire, etc. Así, las bacterias Gram negativas (en adelante, G-) mueren rápidamente en suspensión aérea.
No obstante, puede convertirse en un buen medio de dispersión si los microorganismos disponen de formas de resistencia; esto es lo que ocurre con algunos actinomicetos, especialmente, del género Streptomyces, que han desarrollado pequeñas esporas secas que sobreviven muy bien en el aire.
La flora bacteriana predominante suele estar constituida por bacilos y cocos Gram positivos (en adelante, G+) esporulados y Micrococcus. En algunos ambientes muy específicos, la contaminación del aire llega a ser muy importante en algunas especies; es el caso de las granjas, en las que hay grandes cantidades de esporas de Thermoactinomyces vulgaris y Alicropolyspora faeni, que son responsables de la enfermedad conocida como pulmón del granjero.
Los mohos no disponen de mecanismos activos para la dispersión de sus esporas, pero producen grandes cantidades de ellas, no humedecibles y muy resistentes a la desecación y la luz, y que son transmitidas por el aire como las partículas de polvo por perturbaciones físicas o por el viento; al parecer, esto es lo que ocurre con las esporas de Penicillum y Aspergillus.
Por otra parte, la influencia de la humedad relativa del aire es decisiva en la desaparición de esporas y en la germinación de hongos. En el primer caso se encuentra el género Cladosporium, que elimina sus esporas en las momentos de máxima humedad; en el segundo caso, el Aspergillus repens, cuya germinación favorece el aire húmedo, o el Penicillium cyclopiurn o el Fusarium moniliformis, en los que es el aire seco el que permite que proliferen. Respecto a las levaduras, se debe señalar que raramente se encuentran en suspensión aérea, y destaca sólo el género Torulopsis.
Contaminación de los alimentos a partir del agua
La mayoría de las veces, el agua es un medio privilegiado de proliferación y transmisión de microorganismos. No hay que olvidar que, en superficie y volumen, tanto si es dulce como salada, constituye la mayor parte de la biosfera, y que existen muchas especies de microorganismos adaptados a este hábitat.
Por ello, la calidad microbiológica del agua, directa o indirectamente, ejerce una enorme influencia en la contaminación de los alimentos.
Podemos encontrar en suspensión microorganismos muy diversos, especialmente, bacterias procedentes del suelo, como Streptomyces, Micrococcus, Alcaligerres, Corynebacterium, Pseudomonas, Acinetobacter, Aeromonas, Chromobacteníum o Moraxella. Los animales acuáticos, además de la flora específica típica de su especie, pueden ver aumentada su carga microbiana con estos microorganismos.
Asimismo, en las zonas costeras existen aportes de microorganismos procedentes de actividades humanas que pueden incrementar esta variedad, con gérmenes patógenos de restos fecales de hombres y animales, como las enterobacterias y los enterococos.
Algunos mariscos filtran partículas que proceden del agua, las cuales, si están contaminadas, contaminarán también a estos animales. Así, la hepatitis, la fiebre tifoidea o la gastroenteritis se deben al consumo de bivalvos perfectamente normales en sabor y aspecto.
En aguas cálidas no contaminadas es posible encontrar Vibrio parahemolyticus en mariscos filtrantes, que puede ser responsable de brotes de intoxicaciones alimentarias.
Por otra parte, en la industria se utiliza el agua en múltiples fases de preparación de los alimentos (regado, lavado, pulverizado…), por lo que debe ser do excelente calidad microbiológica. Esto no ocurre siempre, y aparecen contaminaciones posteriores a la fabricación.
Los hongos también están presentes en este medio, pero no tienen la misma relevancia que otros microorganismos. Existen especies específicamente acuáticas y que incluyen algunos de los patógenos de moluscos y peces.
Son importantes en cuanto a la alteración de alimentos los mohos Aspergillus, Penieillium, Rhizopus, Botrytis y Fusarium. No se suelen encontrar levaduras en este medio, por tanto, su intervención en la contaminación alimentaria es pequeña.
Entre los microorganismos fotosintéticos procariotas, las cianobacterias o las algas azul-verdes, y los dinoflagelados, entre los eucariotas, son responsables de alteraciones en la calidad e inocuidad de los alimentos.
Ambos grupos de microorganismos son capaces de producir metabolitos tóxicos en animales acuáticos sin ocasionar, aparentemente, daño alguno, pero, al ser consumidos por el ser humano, pueden provocar intoxicaciones graves.
Contaminación de microorganismos en los alimentos a partir del suelo
Desde el punto de vista microbiológico, se entiende por suelo el conjunto de todas las superficies con las que se puede poner en contacto el alimento, tanto a lo largo de su producción como durante su recolección, transformación, manipulación, almacenado, transporte o comercialización. Como se ve, el concepto incluye muchas espacios muy diferentes con habitat bastante distintos, por lo que al generalizar, en realidad, nos referimos a un medio muy complejo. Los microorganismos que prosperan en el suelo se conocen como telúricos.
El suelo es un reservorio tan rico que de él se han obtenido cepas que se utilizan en la producción industrial de antibióticos, enzimas, aminoácidos, vitaminas y otros productos básicos, tanto para la industria farmacéutica como para la de los alimentos. Además, es un medio muy competitivo con parámetros que pueden cambiar rápidamente y, como consecuencia, los microorganismos habituales en él han desarrollado estructuras resistentes: es el caso de Bacillus y Clostridium.
Para los mohos, éste es un medio habitual de desarrollo o de depósito como formas de resistencia; por este motivo pueden ser fácilmente transmitidos a los alimentos, especialmente, Aspergillus, Penicillium, Rhizopus o Fusarium. Por lo demás, el suelo es el origen de muchas levaduras importantes en la tecnología de alimentos, ya que son las responsables de diferentes fermentaciones; un ejemplo de ello es Saccharomyces.
Contaminación a partir de microorganismos presentes de forma natural en los alimentos
La piel del animal, la cáscara de los huevos, la cubierta de las legumbres, la piel de las frutas… constituyen barreras naturales que los microorganismos no pueden atravesar. Sin embargo; durante alguna de las fases de manipulación y obtención del alimento, estas barreras pueden dejar de ser efectivas o presentar puntos débiles que permitan la entrada de gérmenes al interior del alimento y, así, el acceso a nuestro organismo. Este acceso es más fácil y directo si del alimento se consume también sus pieles o cáscaras.
En los alimentos de origen animal, es posible que la piel y los cueros se pongan en contacto con los tejidos interiores mientras se preparan las canales en los mataderos; la leche se puede contaminar con los microorganismos presentes en las ubres del animal; o, en huevos sometidos a fenómenos de dilatación, al producirse cambios bruscos de temperatura por malas condiciones de almacenamiento, quizás se facilite la entrada de gérmenes. De este modo, cabe encontrar Staphylococcus, Corynebacterium, Propionibacterium, Pseudomonas, Acinetobacter, Proteus o Serratia en zonas no habituales de estos alimentos.
Si se trata de alimentos de origen vegetal, los microorganismos más frecuentes de superficie, responsables de ciertas alteraciones, son los mohos, como Alternaría, Fusarium, Rhizopus, Penicilium, Botrytis, Cladosporium o Aspergillus. En cuanto a bacterias, las más representadas son Erwinia, Flavobacterium, Kurthia, Lactobadllus, Xanthomonas, Streptococcus, Leuconostoc y Pseudomonas. Por su parte, las levaduras son responsables de contaminaciones en menor grado: citaremos Saccharomyces, Rhodotorula, Torula, Sporobolomyces y Bullera.
Además de los microorganismos existentes en la superficie de los alimentos, no hay que olvidar que su interior ofrece habitat específicos para algunos gérmenes que no se suelen poner en contacto con otras regiones del alimento, salvo manipulaciones especiales.
Esto especialmente evidente en los animales; asi por ejemplo, el contenido del tubo intestinal que, en el animal vivo está aislado de las masas musculares, durante el sacrificio, la evisceración y la formación de las canales sí pueden contaminar la carne. De esta forma se pueden diseminar enterobacterias, como Escheirichia, Salmonella, Shigella o Proteus, enterococos, en especial, Streptococcus, y otros como Staphillococcus, lactobacillus, Bacterioides, Pseudomonas o Clostridium.
Por otra parte, hay dos gérmenes de interés creciente pues se les responsabiliza de cuadros de enteritis o septicemias: Campylobacter y Yersinia. Los mohos están poco representados y, entre las levaduras, destaca Cándida. Con mucha frecuencia, la contaminación de tejido muscular se produce por el hecho de que los gérmenes migran por el sistema linfático, lo que favorece las operaciones de duchado y despiece de las canales.
Contaminación por microorganismos a lo largo del tratamiento del alimento
El establecimiento en el que se procesa el alimento y su ambiente constituyen una fuente de nuevas contaminaciones, que se suman a las anteriores. Las principales causas de esta contaminación siguen siendo el aire, el suelo y el agua, a las que hay que añadir la función desempeñada por los equipos industriales, los instrumentos y el personal manipulador.
Estas contaminaciones dependen del diseño de los locales y de las Cadenas de fabricación, del nivel de higiene impuesto por las prácticas de limpieza, de la desinfección y el mantenimiento general de la fábrica, y de las denominadas buenas Prácticas de Fabricación o BPF (Good ManutaiPrácticos, las GMP anglosajonas). Normalmente este tipo de contaminación diversifica los géneros microbianos y hace que aumente globalmente la flora en el producto fabricado.
En la industria alimentaria, el agua es una principales fuentes de contaminación, por el variadísimo uso que se hace de ella, desde el lavado de los alimentos al agua de refrigeración, pasando por la limpieza de los materiales. Igualmente, el contacto directo con el aire es un importante factor contaminador; para minimizar sus efectos se recurre a diferentes técnicas como la aplicación de películas permeables a los gases en el almacenamiento de carnes, o el trabajo en un ambiente de aire filtrado.
Las superficies y, especialmente, los espacios muertos y instalaciones o en las zonas de contacto con los alimentos, permite que se acumulen gérmenes y productos de desecho que pueden convertirse en SUSTRATOS nutritivos para ellos. De la misma forma, las máquinas sus accesorios y conducciones o los pequeños instrumentos de manipulación, como cuchillos o planchas de corte, así como los recipientes y contenedores, son fuentes potenciales de contaminación, por lo que deben ser objeto de un mantenimiento, una limpieza y una desinfección regulares.
El personal manipulador puede ser una fuente de contaminación, sobre todo, si es portador de gérmenes patógenos. No se debe olvidar que, en todos los aspectos que se acaban de indicar existe, además, el riesgo de la contaminación cruzada.
Las transformaciones tecnológicas inciden cuantitativa y cualitativamente sobre la flora microbiana del alimento, al sufrir éste modificaciones en diferentes parámetros: disgregación, cambios de temperatura y de actividad de agua, potencial redox, pH, etc. En algunos casos, estos cambios suponen una disminución de la flora total o la selección de unos microorganismos más específicos para las nuevas condiciones creadas.
La refrigeración limita el crecimiento microbiano al reducir la actividad metabólica de los microorganismos.
Contaminación por microorganismos en el almacenamiento, el transporte y la comercialización
Cualquier modificación en las condiciones de almacenamiento y de transporte puede suponer que proliferen microorganismos contaminantes, por ejemplo, cambios de humedad relativa, la ruptura de la cadena de frío o el aumento de la concentración del oxígeno son algunas de las alteraciones más frecuentes en las que se favorece el crecimiento de gérmenes.
En la etapa de comercialización y distribución de los alimentos también es posible que se contaminen desde el aire, el agua, el suelo, el personal manipulador y las condiciones de manipulado.
De este modo, el cocinado inadecuado, el sometimiento del producto acabado a temperaturas incorrectas, la prolongación de tiempos, desde la preparación a la distribución de la comida, la limpieza y desinfección deficientes y la manipulación por parte de personal infectado, suelen facilitar el desarrollo de gérmenes como Staphilococcus aureus, Clostrídium perfringens o Salmonella sp
El alimento acabado, listo para su consumo, contiene una flora microbiológica que es el resultado de su «historia». Se ha de obtener un producto conforme a las disposiciones legales, de forma que se puedan evitar intoxicaciones y toxiinfecciones que incidan en la salud del consumidor.
Las Buenas Prácticas de Fabricación dan lugar a un producto saludable y con el nivel de calidad esperado.
Factores que influyen en la multiplicación de los microorganismos en los alimentos
Los alimentos, aun con sus estructuras íntegras, pueden sufrir contaminaciones de muy diversos orígenes y convertirse en un medio aceptable de desarrollo de microorganismos en sus superficies. Los productos alimenticios, sean de origen animal o vegetal, suelen estar protegidos del medio exterior mediante tegumentos, piel, cáscaras o conchas, que forman una barrera bastante eficaz a la penetración de gérmenes durante la vida del animal o la planta.
Esta barrera sufre profundas modificaciones o desaparece tras la recolección o el sacrificio del animal por simple descomposición natural, o porque se elimina o se lesiona, con lo que se facilita que gérmenes superficiales invadan el producto.
La estructura interna de los tejidos de los animales suele estar organizada en células separadas por membranas y tejido conjuntivo o en paredes y estructuras celulósicas si se trata de vegetales. Todo esto limita la propagación de los microorganismos a la masa del alimento. Hay productos, como la leche, en los que esta organización no existe, por lo que son bastante vulnerables a la diseminación de gérmenes. Los microorganismos, además, son capaces de segregar ciertas hidrolasas (proteasas, celulasas, pectinasas) con las que destruyen estas barreras y favorecen su penetración.
Tal capacidad se ve favorecida durante el tratamiento de los alimentos, pues las operaciones de pelado, troceado, triturado, prensado, etc., destruyen estas estructuras, dan homogeneidad al producto y favorecen la diseminación y el desarrollo de microorganismos.
Es indispensable conocer los mecanismos de acción de los distintos parámetros que pueden intervenir en la proliferación de microorganismos durante la vida útil del alimento para:
• Inhibir el crecimiento de gérmenes.
• Prever las consecuencias del desarrollo de estos gérmenes.
• Interpretar correctamente las alteraciones sufridas por un alimento.
Estos parámetros influyen sobre el metabolismo y la multiplicación de los gérmenes con modificaciones en la fase de latencia, pendiente de la fase exponencial y duración de la fase estacionaria, antes de la lisis celular, en la curva de crecimiento microbiano.
En la práctica, la situación se complica, pues la microflora de un alimento no está formada por un solo tipo de gérmenes ya que, como se ha indicado anteriormente, las posibilidades y fuentes de contaminación son múltiples, además de que ciertos microorganismos añadidos serán capaces de crecer junto a otros, constituyendo una asociación microbiana, o desplazarán a los ya existentes, originando sucesiones microbianas.
Son muchos los factores que influyen en el crecimiento de los gérmenes en los alimentos, como también lo son sus asociaciones, sucesiones, alteraciones y riesgos para la salud que entrañan. Los clasificaremos en cuatro grandes apartados, siguiendo la propuesta de Mossel e Ingram.
El primer grupo, el de los factores intrínsecos, incluye las características y propiedades fisico-químicas del alimento
El segundo, los factores extrínsecos, remite a las características medioambientales de ese alimento
Los factores implícitos constituyen el tercer grupo e incluyen las propiedades de los gérmenes y de sus posibles interacciones.
Finalmente, el cuarto grupo, los factores de elaboración, algunos autores lo incluyen en el primero, ejercen sus efectos sobre uno o varios de los factores precedentes; así, el troceado producirá alteraciones estructurales que facilitan el acceso a nutrientes, modifican el potencial redox y destruyen estructuras antimicrobianas.
En este apartado nos ocuparemos de los de primeros grupos de factores, por tener un efecto fácilmente generalizable; dejamos los otros dos para su análisis en las unidades que traten de forma específica los diferentes tipos de gérmenes o grupos de alimentos.
Factores que influyen en el desarrollo microbiano de los alimentos
Factores intrínsecos
Disponibilidad de nutrientes
Los microorganismos necesitan agua, fuentes energéticas, nitrógeno, sales minerales y, eventualmente, oxígeno y factores de crecimiento para su desarrollo, y son capaces de utilizar los alimentos para conseguir todos estos elementos esenciales y energía. Si un microorganismo no puede usar un componente que es mayoritario en la composición de un determinado alimento, estará en desventaja respecto a otros que sí son capaces de emplearlo.
Es matemáticamente idéntica a la ecuación de Michaelis-Menten de la cinética enzimática, y expresa la dependencia de la velocidad del crecimiento del microorganismo respecto a la concentración del nutriente limitan habiendo una constante de saturación. Mientras la concentración del nutriente limitante sea mayor que la constante de saturación el microorganismo crecerá a una velocidad próxima a su velocidad máxima de crecimiento. Experimentalmente, existen determinaciones de estos coeficientes para diferentes microorganismo y nutrientes.
Los microorganismos que contaminan los: alimentos, suelen ser quimioorganótrofos y utilizan los hidratos de carbono, más que los ácidos grasos o las sustancias nitrogenadas, como fuente energética, pero sólo los monómeros o moléculas más pequeñas son capaces de atravesar la membrana de los gérmenes, mientras que los polímeros deben hidrolizarse previamente.
Así, la capacidad de sintetizar enzimas amilolíticos favorecerá el crecimiento de unos determinados microorganismos en cereales y derivados farináceos, en detrimento de otros que no pueden sintetizarlos.
Los productos alimenticios contienen, en general, todos los nutrientes precisos para el desarrollo de microorganismos, pero las diferencias de composición que se observan ejercen un efecto selectivo sobre su flora microbiana.
Incidencia del pH
El hecho de que el medio en el que se desarrolla un microorganismo sea alcalino o ácido tiene una gran influencia en la estabilidad de macromoléculas, como enzimas o proteínas, o en iones; por ello, no es de extrañar que el crecimiento y el metabolismo de los gérmenes estén determinados por el pH.
La representación gráfica de la velocidad de crecimiento microbiano frente al pH origina una curva campaniforme aproximadamente simétrica con una amplitud de dos a cinco unidades de pH, y presenta su máximo crecimiento a lo largo de una a dos unidades.
La mayoría de las bacterias se desarrollan entre un pH de 4,5 y 9, con un óptimo de crecimiento comprendido entre 6,5 y 7,5. Existen excepciones, como las bacterias acéticas y lácticas, que pueden soportar pH inferiores a 3,5.
La mayoría de los hongos son ácido-resistentes, y tienen un óptimo de crecimiento que oscila entre 4 y 6, existiendo valores extremos de 2 a 9 para las levaduras y de 2 a 11 para los mohos.
Dentro de las bacterias patógenas, los géneros Vibrio y Clostridium son más sensibles a las variaciones de pH que el resto de bacterias. E Coli, Salmonella y Staphylococcus son los más resistentes, aunque, con grandes cambios de pH, sufren fuertes reducciones de crecimiento, como ocurre en el Staphylococcus aureus.
Clostridium botulinum es un microorganismo muy estudiado en relación a su supervivencia en medios con diverso pH; así, se sabe que a un pH inferior a 4,5 no hay crecimiento del germen ni producción de toxina, si bien se han descrito algunos casos en los que el germen se encontraba en medios muy ricos en proteínas a pH de 4.
Se ha puesto también en evidencia la influencia de la naturaleza del ácido predominante en el medio y su acción tóxica para los gérmenes; de este modo, el acetato es más tóxico que el lactato, y mucho más que el citrato.
En general, toda disminución de pH provoca un descenso de la tasa de esporulación, que se hace muy débil por debajo de 6, lo mismo que la termorresistencia de gérmenes y de esporas, lo que permite disminuir el tiempo de actuación del calor para destruir gérmenes si se encuentran en un medio ácido.
La acción del pH sobre el crecimiento de los microorganismos se puede considerar a tres niveles: sobre el medio, sobre la permeabilidad de membrana y sobre la actividad metabólica. La disponibilidad de nutrientes en el medio sufre modificaciones en función del equilibrio iónico.
Así, los iones de Mg a pH ácido forman complejos insolubles; en el caso del Zn, Ca o Fe ocurre en pH básico. De cualquier manera, resultan difícilmente utilizables como cofactores de enzimas indispensables.
Por otra parte, la permeabilidad de la membrana también se ve afectada por las variaciones de concentración de H’1′ y OH». En un medio ácido, las permeasas catiónicas se saturan con iones hidrógeno, lo que limita o anula su capacidad de transporte de cationes.
En un medio alcalino, son los iones hidroxilo los que saturan la membrana, impidiendo la transferencia de aviones.
Las reacciones enzimáticas presentan un optimo de actividad, por encima y por debajo del cual su estructura puede verse afectada y su cinética sufrir cambios, lo que altera la velocidad de crecimiento del germen. No todos los enzimas tienen la misma sensibilidad a estos cambios.
A esto hay que añadir que plasma celular está parcialmente protegido frente a estos cambios extracelulares: por una parte, la membrana es poco permeable a moléculas fuertemente iónica como los H+, y por otra, parte el citoplasma tiene una capacidad tampón bastante eficaz.
En general, es posible afirmar que las modificaciones más importantes se producen dentro de valores de pH neutro o ácido, al encontrarse la mayoría de los alimentos dentro de estos valores de pH, pues los productos más alcalinos originan sabores desagradables. No obstante, existen algunas excepciones, como la clara del huevo, que puede llegar a valores de pH de 9,2 a medida que se va eliminando el C02 tras la puesta.
Potencial de óxido reducción y oxígeno
Un medio es oxidante cuando captura electrón y es reductor cuando los cede. El potencial redox (Eh) en voltios mide la facilidad por la cual el medio pierde electrones.
Un medio será reductor cuando contenga substancias muy hidrogenadas, radicales – SH, azucares reductores u otras sustancias, como el ácido ascórbico o el tocoferol, lo que ocurre en bastantes productos alimentarios. . El oxígeno atmosférico, ya sea en la superficie o en el interior del producto, atrapado en la masa o en los parénquimas vegetales, hace que estos productos tengan un potencial redox positivo (Eh) positivo.
A medida que en un alimento cambian las condiciones redox, el potencial redox ofrece una cierta resistencia a modificarse, lo que se conoce como equilibrio. El fenómeno es parecido al efecto tampón en el pH, y se justifica por la gran cantidad de sustancias donadoras y/o receptoras de electrones que existen.
El potencial redox tiene un efecto fundamental sobre la microflora de un alimento. Aunque el crecimiento microbíano se puede producir dentro de un amplio margen de potencial redox, los microorganismos se suelen encuadrar dentro de un intervalo de potencial, dentro del cual son capaces de crecer. De este modo, se establecen cuatro grupos principales de gérmenes:
Aerobios estrictos, por ejemplo, Pseudomonas, Micrococcus y Bacillus. Necesitan oxígeno como aceptor final de electrones y un elevado Eh,; no pueden servirse de una vía fermentativa y carecen de catalasas para eliminar el peróxido de hidrógeno. Predominan en la superficie de los alimentos o en aquellas zonas en las que el aire se pueda utilizar fácilmente.
Aerobios facultativos, por ejemplo, las enterobacteriáceas o Staphylococcus. Pueden desarrollarse en presencia o en ausencia de oxígeno, tienen cadena respiratoria, enzimas de fermentación y son catalasa positivos. En anaerobiosis suelen tener una menor tasa de crecimiento o sus exigencias en factores esenciales son mayores, con respecto al grupo anterior
Anaerobios estrictos, como Clostridium, Bacterioides, Peptococcus y Propionibacterium. Necesitan potenciales redox bajos o negativos, tienen un metabolismo fermentativo, son catalasa negativos y quedan inactivados de forma variable por la presencia dé oxígeno, según sea la presión parcial del mismo.
Microaerófílos o aerotolerantes, por ejemplo, Lactobacillus, Streptococcus o Pediococcus. Son incapaces de respiración aerobia, pero crecen en presencia de aire; carecen de catalasas, aunque pueden destruir los productos tóxicos del oxígeno mediante un mecanismo de acumulación de pequeñas concentraciones de manganeso.
El oxígeno influye sobre el valor de Eh, de un medio, pero también actúa específicamente en el metabolismo. Así es utilizado por algunos microorganismo como acepto final de electrones; por otra parte, es responsable de la formación de peróxido de hidrógeno por la flavoproteínas de la cadena cadena transportadora de electrones.
Igualmente, puede actuar sobre el equilibrio de muchas reacciones; de este modo, en el ciclo de los ácidos tricarboxílicos, los productos de reacción tienen un Eh, cada vez más elevado. Un Eh, muy positivo favorece reacciones en sentido de oxidación, mientras que un Eh, negativo puede inhibirlas o, incluso, invertir el ciclo.
Los microorganismos que se desarrollan en presencia de oxígeno disponen de dotaciones enzimáticas adecuadas para descomponer los productos tóxicos que se derivan del metabolismo aerobio, como las catalasas, que descomponen el peróxido de hidrógeno, o la superóxido dismutasa, capaz de degradar el anión superóxido muy tóxico, producido por las flavoproteínas.
El crecimiento microbiano en un alimento reduce su Eh,; este efecto se suele atribuir a la asociación del agotamiento del oxígeno con la producción de compuestos reductores por los microorganismos, aunque parece ser que el principal mecanismo es el primero que se ha explicado.
La disminución de Eh, como consecuencia de la actividad de los microorganismos en los alimentos es el fundamento de algunas pruebas rápidas que se idearon hace tiempo y que se aplican en algunos alimentos, especialmente, en productos lácteos.
Para poner de manifiesto cambios de Eh, en función de los niveles de gérmenes, se pueden usar colorantes sensibles a variaciones del potencial redox, como el azul de metileno o la resazurina.
El azul de metileno también se emplea para calcular el porcentaje de células viables de levaduras en la fabricación de la cerveza. Si se tiñe con este colorante una suspensión de células de levadura y se lleva al microscopio, se observará que las células viables tienen capacidad reductora en su citoplasma y que aparecen incoloras, mientras que las células no viables toman un color azul.
Actividad del agua
Un alimento es un sistema complejo en el que pueden existir niveles estructurales intrincados, como las células animales o vegetales, complejos moleculares muy dispares en los que hay interacciones diferentes, agregados moleculares con uniones más o menos débiles ,iones, etc. El único punto que tienen en común todos estos elementos es su relación con la presencia de agua, ya sea como disolvente de algunos de ellos, ya como elemento estructural de otros, ya como medio de dispersión de los demás.
Al hablar del contenido acuoso de un alimento, es fácil hacerse una idea si pensamos en una fruta con una pulpa rica en zumo, en una preparación de tipo gel o, incluso, en un trozo de carne, pero la tarea se hace más difícil cuando nos referimos a frutos secos, a galletas, a alimentos desecados o a harinas. Sin embargo, en estos últimos existen también existe un cierto contenido acuoso.
Precisamente la complejidad estructural de estos alimentos hace que el agua que contienen pueda estar presente en muchos niveles de su estructura. Para tratar de sistematizar estos contenidos acuosos se han propuesto diferentes definiciones tales como las que siguen:
Agua de la fase masiva (libre o atrapada) agua más fácilmente extraíble que hay en los alimentos, con propiedades similares al agua de una solución y una gran capacidad solvente, de evaporación y congelable. Permite velocidades rápidas para la mayoría de reacciones químicas y puede suponer hasta el 96% de agua de alimentó con humedad alta.
Agua multicapa. Como su nombre indica, agua que forma varias capas en torno a grupos hidrofilicos de constituyentes no acuoso esta asociada a moléculas vecinas por enlaces de hidrógeno, su capacidad solvente es moderada y es más difícil de evaporar que el agua del agua masiva. En su mayor parte, no es congelable permite algunas reacciones restringidas y representa del 1% al 5% del agua total de un alimento.
Agua de constitución (o ligada). Forma parte integral de constituyentes no acuosos, por ejemplo los intersticios de las proteínas o el agua de hidratación molecular, y está fuertemente unida estos constituyentes. Carece de capacidad solvente se evapora muy difícilmente, sólo permite reacciones de autooxidación y supone menos del 1 % del agua total.
Desde hace mucho tiempo se sabe que existe relación entre el contenido en agua de un alimento y su alterabilidad. También se ha observado que diferentes alimentos con el mismo contenido en agua difieren considerablemente en cuanto a su susceptibilidad a la alteración. Esto significa que el contenido en agua por sí solo, no es un indicador fiable de la alterabilidad del alimento.
Donde P es la presión parcial en equilibrio con el sustrato y p0 la presión parcial en equilibrio con el agua pura.
La aw, por tanto, nos indica la disponibilidad de agua de un determinado medio para las reacciones químicas, las bioquímicas, los cambios de estado o las transferencias a través de membranas semipermeables.
Su valor oscila entre O y 1.
Cuando se reduce la aw, del medio, disminuye de forma paralela el número de grupos de microorganismos capaces de crecer activamente (Cuadro 4.2). El intervalo preciso de aw, que permite el crecimiento está influido por diferentes parámetros.
Actividades de agua mínimas para crecimiento activo de distintos microorganismos.
Grupos de microorganismos aw mínima
Mayoría de bacterias G- 0,97
Mayoría de bacterias G+ 0,90
Mayoría de levaduras 0,88
Mayoría de hongos filamentosos 0’80
Hongos xerófilos 0,61
Los microorganismos se suelen organizar en tres grandes grupos, dependiendo del principal producto responsable de las modificaciones de la aw en el medio:
Halófilos o halotolerantes. Pueden crecer en presencia de elevadas concentraciones de sal.
Osmófilos u osmotolerantes. Son capaces de crecer con elevadas concentraciones de compuestos orgánicos no ionizados, como los azúcares.
Xerófilos oxerotolerantes. Tienen capacidad para crecer en alimentos con una aw, muy baja.
Componentes antimicrobianos
Puesto que la mayor parte de los alimentos tienen su origen en seres vivos, las barreras antimicrobianas que protegían al organismo del que provienen serán las primeras defensas frente a la proliferación de gérmenes.
Así, los sistemas de protección o de cobertura, como la piel, la cáscara, la vaina o la corteza, ofrecen un primer impedimento a la contaminación. Se suele tratar de estructuras constituidas por macromoléculas que son bastante resistentes a las agresiones, sean físicas, químicas o biológicas, debido a sus características de insolubilidad, de uniones moleculares específicas o de resistencia a enzimas ( es el caso de las queratinas, las celulosas o las ligninas).
Tienen una baja aw, escasos nutrientes accesibles y, en muchos casos, sustancias antimicrobianas, como los ácidos grasos de cadena corta en los animales o los aceites esenciales o las ceras en los vegetales.
Una vez superada esta primera barrera, es posible que los tejidos contengan productos antimicrobianos los cuales, además, se pueden concentrar localmente a consecuencia de daños fisicos en los tejidos; recordemos aquí una de las funciones del pardeamiento enzimático en los vegetales.
Existe el mismo sistema de liberación de enzimas y de sustratos por rotura de tejidos pero con fines específicamente antimicrobiano en algunas plantas, como la mostaza o el rábano picantes que producen ísotiocianatos; en especies del genero Allium (ajo, cebolla o puerro), productoras de tiosulfinatos como la allicina, o compuestos antimicrobianos conocidos globalmente como fitoalexinas, con faseolina de las judías verdes, un antifúngico.
Otra sustancias tienen un espectro más amplio, como la acción del gosipol, presente en las semillas de algodón, antibacteriano y antifúngico.
Existen otros compuestos activos en los tejidos tales: los pigmentos, los alcaloides, las resinas o los aceites esenciales, así como, también en la mayoría de plantas, y se utilizan como condimentos: el timol del tomillo y el orégano, el eugenol en el clavo…
Los productos de origen animal también con compuestos antimicrobianos de carácter inespecíficos. Unos son de acción directa, como la lisozima del albumen del huevo, que hidroliza los enlaces glucosidicos de los péptidoglicanos de la pared bacteriana ejercen una acción indirecta, al disminuir la disponibilidad de nutrientes esenciales para los microorganismos es el caso de la ovoferrina del huevo o de la lactotransferrina de la leche, que agotan el hierro del medio; o de la avidina y la ovoflavoproteína, que bloquean la biotina y la riboflavina.
FACTORES EXTRÍNSECOS
Humedad relativa
La humedad relativa (HR) representa la proporción de vapor acuoso existente en un volumen atmosférico dado, en relación con la cantidad que se necesita para obtener la saturación. Es un parámetro que se tener en cuenta, ya que la aw del alimento y la humedad relativa del ambiente al que está expuesto, siendo HR, esencialmente, una medida de aw, en fase gaseosa.
Así, un alimento de baja aw, almacenado en una atmósfera con una HR elevada, tiende a establecer un equilibrio, y el agua de la fase gaseosa pasa al alimento. El proceso puede ser muy lento, pero es posible que se generen zonas superficiales de condensación de agua en las que prosperen gérmenes que, hasta ese momento, estaban en estado latente. A su vez, la actividad metabólica y respiratoria de estos gérmenes puede generar una mayor a.v, en el medio ambiente próximo, favoreciendo el crecimiento de otras especies.
Por otra parte, también hay que tener en cuenta que la HR es muy sensible a la temperatura: con temperaturas altas, tiende a disminuir, y con temperaturas bajas tiende a aumentar, potenciando los fenómenos de condensación.
Estas variaciones de humedad son especialmente aprovechadas por mohos y levaduras, lo que obliga a la conservación de alimentos secos en ambientes con una humedad relativa muy baja.
Temperatura
La temperatura es uno de los factores fundamentales que influyen en el crecimiento de los microorganismos, ya sea de forma directa, por las alteraciones que sufre el germen a diferentes temperaturas, o de forma indirecta, puesto que los cambios de temperatura repercuten en una gran parte de los factores analizados en esta unidad incrementando 0 disminuyendo su eficacia. Por eso, es el principal parámetro en la conservación de los alimentos.
La mayoría de los microorganismos proliferan a temperaturas iguales o superiores a 20°C, aunque se admite que las células microbianas pueden crecer a temperaturas comprendidas entre -18°C y 100°C.
A estos valores extremos, el crecimiento es muy limitado, pero la actividad metabólica del germen puede ser significativa; así, por ejemplo, se ha demostrado actividad lipásica en Pseudomonas fragi al cabo de 21 días de incubación a 21 °C.
Cada organismo presenta una temperatura óptima, a la cual, sus funciones metabólicas y, por tanto, su capacidad de crecimiento, tienen un rendimiento máximo. Por encima y por debajo de ella existen unos márgenes de temperatura dentro de los que es posible una proliferación y una actividad significativas del germen.
Estos valores se conocen como temperaturas cardinales. La zona comprendida entre la temperatura mínima y la máxima es la zona eugénica, las temperaturas inferiores o superiores a las de la zona eugénica, respectivamente, constituyen la zona disgénica de temperaturas para un microorganismo dado.
Este rango de temperaturas es típico para un determinado microorganismo, aunque está influido por factores ambientales, como la disponibilidad de nutrientes, el pH o la aw.
Si representamos gráficamente la velocidad de crecimiento de un germen cualquiera en función de la temperatura, obtendremos una curva, en ella se observa un máximo de crecimiento a una temperatura dada; este máximo será su temperatura óptima.
Además, la curva es asimétrica, decreciendo rápidamente por encima de esa temperatura; mientras, por debajo de ella, el crecimiento es más lento.
Estos fenómenos se pueden explicar por el retardo de la actividad de los complejos enzimáticos que actúan en la célula antes de alcanzar la temperatura óptima, por eso, el crecimiento es progresivo, pero lento, así como también por la desnaturalización proteica y el desmoronamiento de la membrana celular por encima de la misma, lo que produce una drástica disminución del crecimiento del microorganismo.
De acuerdo con todo esto, los microorganismos se han clasificado en varios grupos fisiológicos (Cuadro4.3). No obstante; hay que tener en cuenta que esta clasificación se ha convenido, porque es una herramienta útil, pero, en realidad, la distribución de los microorganismos en los intervalos de temperatura es continua.
Grupos de gérmenes según sus temperaturas cardinales.
Grupos
Temperaturas (°C) Mínima Óptima Máxima
Termófilos 40-45 55-75 60-90
Termótrofos 15-20 30-40 45-50
Mesófilos 5-15 30-40 40-47
Psicrófilos -5-+0 12-15 15-20
Psicrótrofos -5-+5 25-30 30-35
Los grupos son éstos:
Psicrófilos. Son microorganismos que proliferan a temperaturas bajas. Espontáneamente, no se suelen encontrar en los alimentos, salvo en regiones geográficas frías o en alimentos a baja refrigeración. Se desarrollan bien desde los 0°C, siendo su temperatura óptima la que oscila entre 12°C y 15°C.
Abarcan diferentes especies, las bacterianas más importantes son Pseudomonas, Alcaligens, Erwinia, Corynebacterium, Flavobacterium, Lactobacillus y Sterptomyces. La mayor parte de las levaduras y de los mohos son psicrótofos.
Mesófilos. Estamos ante microorganismos que se desarrollan en unas temperaturas comprendidas entre 15°C y 40°C, con una óptima de 30°C a 40°C, aunque la mayoría de ellos o los más importantes lo hacen a 37°C. Su tasa de crecimiento es elevada y la duración de su proliferación, relativamente corta (de uno a seis hasta llegar a la fase estacionaria (Fig. 4.4).
Se encuentran en alimentos que están a temperatura ambiente o refrigerados en los que se ha roto la cadena del frío. Es el grupo más importante dé microorganismos, pues comprende la mayoría de las especies patógenas para los humanos y los animales, así como una gran número de las especies saprofitas.
Termófilos. Son microorganismos capaces de proliferar a altas temperaturas, con óptimos que oscilan entre 55°C y 75°C. Tienen una tasa de crecimiento muy alta, pero muy corta. Se pueden encontrar tanto en el aire como en agua o el suelo. En los alimentos los principales géneros bacterianos son Bacillus y Clostridium; entre los mohos Aspergillus, Cladosporiu, Thadmnidium
Dentro de los microorganismos termófilos es posible incluir a los termótrofos, que son mesofilos que se pueden desarrollar a temperaturas elevadas, como ocurre con algunas bacterias lácticas, por ejemplo, Streptococcus thermoplus, Lactobacillus bulgaricus que se multiplican a 45°C, o bacterias fecales, como Streptococcus faecalis, que lo hace a 50°C
La termorresistencia no está necesariamente a la termofilia; por eso, algunos mohos mesófilos Aspergíillus, o ciertas bacterias esporuladas mesófilas como Bacillus cereus, pueden soportar temperaturas relativamente altas para su grupo.
En cuanto a la resistencia a las bajas temperaturas hay que señalar que la mayor parte de los microorganismos aguantan mejor los tratamientos de congelación rápidos que los lentos.
Según la explicación mas aceptada, esto se debe a que los microcristales intracelulares que se forman en la congelación rápida son más pequeños que en la congelación lenta, en la que se originan grandes cristales que destruyen o lesionan estructuras vitales para las células.
De todas formas, en los procesos de congelación siempre hay lesiones, deformaciones o destrucción de elementos celulares, lo que ocasiona una mayor o menor mortalidad de gérmenes. En general, cabe afirmar que las bacterias G+ son más resistentes que las G-.
Igualmente, la resistencia a las bajas temperaturas varía con la forma del germen; así, las células esporuladas de Clostridium tienen una supervivencia de un 38% a-18°C a los tres meses de almacenamiento, mientras que sus formas vegetativas sólo presentan un 4% de supervivencia.
El tiempo de almacenamiento también influye en la supervivencia, pues en muchos microorganismos la mortalidad crece a lo largo del tiempo. En la Figura 4.5. es visible el aumento de la mortalidad en el género Proteus durante su conservación a 18°C’.
Los efectos de la temperatura sobre el crecimiento de los microorganismos se deben, por una parte, a las modificaciones que causa en el estado físico del agua en un medio y, por ello, a su mayor o menor disponibilidad para el germen, la congelación y ebullición disminuyen la fracción líquida, con las consiguientes alteraciones celulares que esto supone.
Además, la temperatura influye en la velocidad de las reacciones químicas y bioquímicas y, por tanto, en la tasa de crecimiento y en el tiempo de generación; igualmente, puede ejercer una acción diferencial sobre diferentes rutas metabólicas y producir cambios de tamaño celular, secreción de toxinas, formación do moléculas, etc.
Es posible explicar las diferencias de estabilidad de los gérmenes a distintas temperaturas por la resistencia o labilidad de sus sistemas enzimáticos a unas temperaturas dadas.
De este modo, la malonato deshidrogenasa de los bacilos termófilos es estable a 65°C durante 120 minutos, mientras que en Bacillus subtilis, se inactiva rápidamente a esta temperatura.
Asimismo, las proteínas de membrana, los ribosomas y los flagelos son bastante termoestables en los microorganismos termófilos, mientras que en los psicrófilos son más termolábiles y se inactivan alrededor de 30°C.
Atmósfera gaseosa
El gas más importante que está en contacto con los alimentos es el oxígeno; Los restantes gases mayoritarios en la atmósfera, el nitrógeno y el C02, desplazan al oxígeno, pero el CO2,además, tiene algunos efectos específicos, especialmente, bactericidas o bacteriostáticos, que analizamos a continuación.
El CO2 actúa uniformemente sobre los diferentes microorganismos; los mohos y las bacterias G- son muy sensibles a su, presencia; las G+, especialmente, los lactobacilos, tienden a ser resistentes. De igual forma. algunas levaduras, por ejemplo; Brettanomyces spp. también presentan tolerancia, incluso, a concentraciones elevadas, por lo que son uno de los constituyentes principales de la microflora que altera las bebidas carbónicas..
Para algunos microorganismos, el C02, tiene un efecto letal pero, su efecto principal es bacteriostático.
Esto se debe a una asociación de varios procesos que aún deben ser estudiados en profundidad. Uno de ellos, que se presenta frecuentemente, es consecuencia de la solubilidad de este gas en agua, lo que origina ácido carbónico y produce modificaciones del pH. Asimismo, es posible que actúe como los ácidos orgánicos débiles, atravesando la membrana citoplasmática y acidificando el interior de la célula.
Se cree que también puede intervenir en otros procesos, como la modificación de las propiedades físicas de la membrana, alterando el transporte de solutos; la inhibición de enzimas esenciales, especialmente, los que intervienen en procesos de carboxilación decarboxilación; o reaccionando con grupos amino de proteínas, modificando sus propiedades y su actividad.
Factores implícitos
El crecimiento y la proliferación de los microorganismos sobre el alimento, cambia su composición y algunos de sus parámetros físico-químicos, por ejemplo, el pH, la aw, etc. La actividad metabólica de los gérmenes modifica el contenido de algunos nutrientes o aumenta la presencia de otros como productos residuales, que pueden actuar como sustancias antimicrobianas, impidiendo el crecimiento de otros tipos de microorganismos, o como sustratos necesarios para garantizar la presencia de otros.
La consecución de todas estas transformaciones es la modificación del equilibrio de la microflora o la aparición de fenómenos de sucesión microbiana por efectos de sinergismos y de antagonismo.
Estos efectos no son siempre perjudiciales; ya algunos se aprovechan para obtener nuevos productos alimenticios o para realizar el acabado final de otros;
AGENTES BACTERIANOS CON SIGNIFICACIÓN EN ALIMENTACIÓN
EL ALIMENTO COMO FACTOR DE RIESGO DE ENFERMEDAD.
- SALMONELLA
- ESTAFILOCOCOS.
- ESCHERICHIA COLI
- CLOSTRIDIOS.
- BRUCELLAS.
- BACILLUS CEREUS.
- SHIGELLAE.
- VIBRIONES.
OTROS AGENTES BACTERIANOS.
FLORA DE LOS ALIMENTOS.
El alimento como factor de riesgo de enfermedad
Un alimento puede ocasionar enfermedades en individuos o ser responsable de brotes epidémicos en colectividades por alguno de los siguientes motivos:
Se comporta directamente como un tóxico a causa de sustancias químicas presentes en su composición.
Es contaminado accidentalmente por tóxicos.
Se le añaden sustancias, para conservarlo o modificar sus características, que se comportan como tóxicos.
Existen en él gérmenes que, por su proliferación, por la elaboración de toxinas o ambas cosas, son capaces de desarrollar cuadros clínicos de enfermedad.
Teniendo en cuenta estos posibles orígenes de afecciones relacionadas con los alimentos, cabe hablar de tres grandes grupos de enfermedades:
Intoxicaciones alimentarias. Se producen como consecuencia de la ingestión de alimentos en los que hay sustancias tóxicas de origen biótico o no. Puede tratarse de restos de pesticidas en un vegetal, de contaminación de un molusco por metales pesados vertidos al mar, de sustancias elaboradas por el metabolismo normal constituyentes del alimento que resultan tóxicas para el ser humano, o de la presencia de toxinas producidas por microorganismos presentes en el alimento, aunque estos gérmenes, per se, no sean patógenos para el ser humano.
Infecciones transmitidas por alimentos. Se deben a la presencia en el alimento de microorganismos patógenos quelo colonizan, se multiplican e invaden el organismo o el propio alimento desencadenando un cuadro típico de la infección correspondiente, sin que se evidencie la producción de ningún tipo de toxina por parte del germen.
Toxiinfecciones alimentarias. Se originan al ingerir alimentos en los que hay microorganismos patógenos que, además de multiplicarse e invadir el organismo, producen toxinas. En muchas ocasiones, se habla tanto de infecciones transmitidas por los alimentos como de toxiinfecciones alimentarias para hacer referencia a cuadros clínicos ocasionados por microorganismos.
A pesar de que los brotes epidémicos de enfermedades relacionadas con los alimentos son de distribución universal, hay predilecciones geográficas condicionadas por la ecología de los agentes causales, el tipo de alimentos, las costumbres de preparación y consumo y las condiciones de vida e higiene ambiental de la comunidad.
En general, se detecta un incremento importante de estos cuadros, tanto en países en vas de desarrollo como en desarrollados.
Los microorganismos aislados con más frecuencia son los del género Salmonella, seguidos de Staphylococcus, Escherichia Coli, Shigella y Clostridium Perfringens.
Entre los alimentos, los que suelen estar implicados son las mayonesas y otros productos en cuya composición está el huevo; siguiendo en importancia las productos de repostería, las carnes, los quesos, los pescados y mariscos y las conservas caseras.
Los factores epídemiológicos que contribuyen a la aparición de brotes de enfermedad se pueden sintetizar en los grupos que siguen:
Conservación de los producidos a temperatura ambiente, a una temperatura inadecuada o con refrigeración insuficiente.
- Existencia de manipuladores portadores de infección.
- Preparación de los alimentos en grandes cantidades y con gran antelación a su consumo.
- Cocción insuficiente de alimentos contaminados o escaso recalentamiento.
- Uso de restos alimenticios
- Descongelación defectuosa.
- Consumo de productos contaminados preparados industrialmente.
- Consumo de alimentos crudos contaminados.
- Contaminaciones cruzadas.
- Limpieza y desinfección insuficientes de utensilios y de materiales de cocinado.
- Empleo de tuberías o de útiles fabricados con productos tóxicos.
- Adición accidental o voluntaria de productos tóxicos en los alimentos.
Asimismo, existe una clara relación entre las estaciones del año y la aparición de brotes, de modo que son especialmente frecuentes entre junio y septiembre, y agosto es el mes en el que más procesos se declaran.
Los microorganismos, pertenecerán a los cinco grandes grupos en los que se clasifican: bacterias, hongos, virus, protozoos y parásitos: además, se pueden presentar como agentes de contaminación y productores de enfermedad, o como microorganismos útiles para la producción del alimento.
Descargo de responsabilidad
Hemos realizado todos los esfuerzos posibles para garantizar que la información proporcionada sea precisa, actualizada y completa, pero no se ofrece ninguna garantía al respecto.
Esta información es un recurso de referencia diseñado como un complemento y no un sustituto de la experiencia, habilidad, conocimiento de los profesionales de la salud, ni pretende ser un diagnóstico ni una terapia referenciada.
La ausencia de una advertencia para un determinado suplemento/alimento o la combinación de los mismos no debe interpretarse de ninguna manera como una indicación de seguridad, eficacia o idoneidad para un paciente determinado.
Conclusión
La microbiología de los alimentos es esencial para la seguridad alimentaria. El control de factores intrínsecos y extrínsecos permite prevenir contaminaciones y reducir el riesgo de enfermedades transmitidas por alimentos.
Ultimos artículos publicados
Bibliografía y fotos:
- Repositorio de fotos de canva
- Apuntes personales de Microbiología